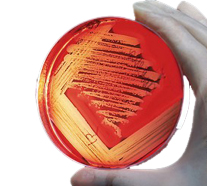

Trabalhamos com os melhores solventes do mercado, que vem de uma ampla linha, com uma sublime pureza de produtos químicos e longas especificações, resultando em produtos de ponta, extremamente confiáveis, para os mais diversos usos. Os solventes distribuídos pela Hexágono Química incluem solventes que podem ser usados tanto para aplicações complexas quanto individuais, contando inclusive com solventes voltados para análise e síntese clássicas, análises instrumentais, e propósitos de produção.
Por ser extremamente eficiente, oferecemos solventes que não só atendem suas necessidades de forma precisa, mas também com economia de tempo e total conveniência, além de completa flexibilidade e uma confiabilidade inigualável. Certamente, ao escolher a Hexágono Química como sua distribuidora, saiba que sempre receberá somente o melhor dos produtos.
Meios de cultura, bem como os itens necessários para tais, não podem ser produzidos por qualquer compania, pelo menos não de forma satisfatória. Na Hexágono Química, tenha certeza de que os produtos vendidos não só possuem uma qualidade comprovada e incomparável, mas também são capazes de atender a qualquer de suas exigências.

Qualquer produto, por mais complexo ou simples que seja, tem sua qualidade determinada pela matéria prima usada em sua fabricação. Orgulhamo-nos de fornecer apenas a melhor das matérias primas, obtidas após um rigoroso processo de sele¸ão.
Claramente, precisando de matérias primas para seu trabalho, saiba que a Hexágono Química é a escolha mais certa para suas vontades e pedidos.

Para diversas tarefas diárias, realizadas em laboratórios, necessita-se de reagentes de qualidade. Os reagentes, variando de analíticos para inorgânicos, são providos não apenas de excelentes atributos, mas também são reconhecidos mundialmente devido à sua aprovação em padrões internacionais, necessitando também de menor esforços para validação.
Providos de alta coerência, reprodutibilidade, qualidade, e pureza, os reagentes vendidos pela Hexágono Química são apropriados para o que precisa, feitos com o cliente em mente.